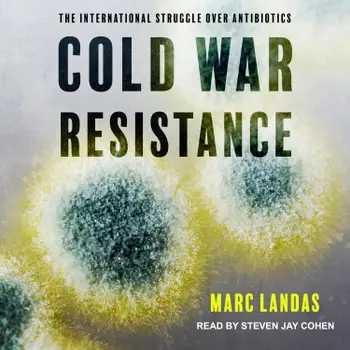

In Cold War Resistance Marc Landas uncovers the dark history behind the discovery, production, and distribution of penicillin and other antibiotics.
Cold War Resistance
Teste 20 Stunden gratis
- Heute lesen und hören
- Keine Verpflichtungen, du kannst jederzeit kündigen

Mach aus jedem Moment ein Abenteuer
- Trag Hunderttausende von Geschichten direkt in deiner Hosentasche
- Keine Verpflichtungen, du kannst jederzeit kündigen

Starten Sie noch heute mit diesem Buch für CHF 0
- Hol dir während der Probezeit vollen Zugriff auf alle Bücher in der App
- Keine Verpflichtungen, du kannst jederzeit kündigen
Autor*in:
Sprecher*in:
Sprache:
Englisch